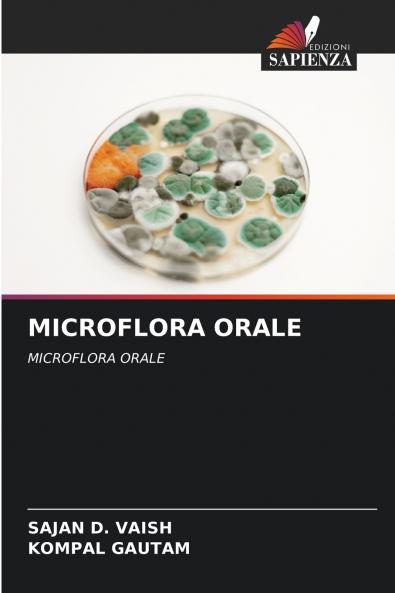
MICROFLORA ORALE

Italian
Paperback
₹6717
₹8689
22.7% OFF
(All inclusive*)
Delivery Options
Please enter pincode to check delivery time.
*COD & Shipping Charges may apply on certain items.
Review final details at checkout.
Looking to place a bulk order? SUBMIT DETAILS
About The Book
Description
Author(s)
La cavità orale è uno degli habitat microbici più complessi. Nel corpo umano la terminologia utilizzata per descrivere i microrganismi presenti nella cavità orale si riferisce alla microflora orale. In futuro potrebbe essere possibile indirizzare il trattamento in modo più specifico verso particolari agenti patogeni o potrebbero essere utilizzati approcci più fantasiosi per prevenire la malattia. In questo contesto il risultato dell'attuale studio clinico con ceppi di S. Mutans produttori di batteriocine non acidogeni ma leggermente competitivi sarà di grande importanza.
Delivery Options
Please enter pincode to check delivery time.
*COD & Shipping Charges may apply on certain items.
Review final details at checkout.
Details
ISBN 13
9786208220532
Publication Date
-23-10-2024
Pages
-80
Weight
-122 grams
Dimensions
-152x229x4.87 mm